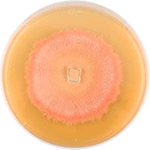
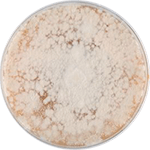
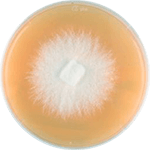
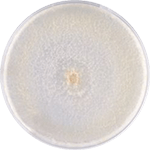
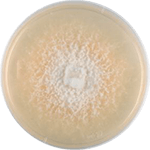
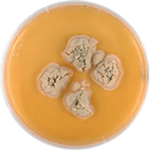
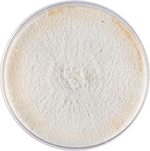
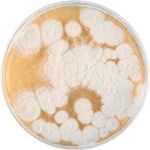
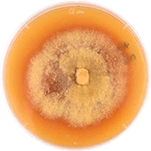
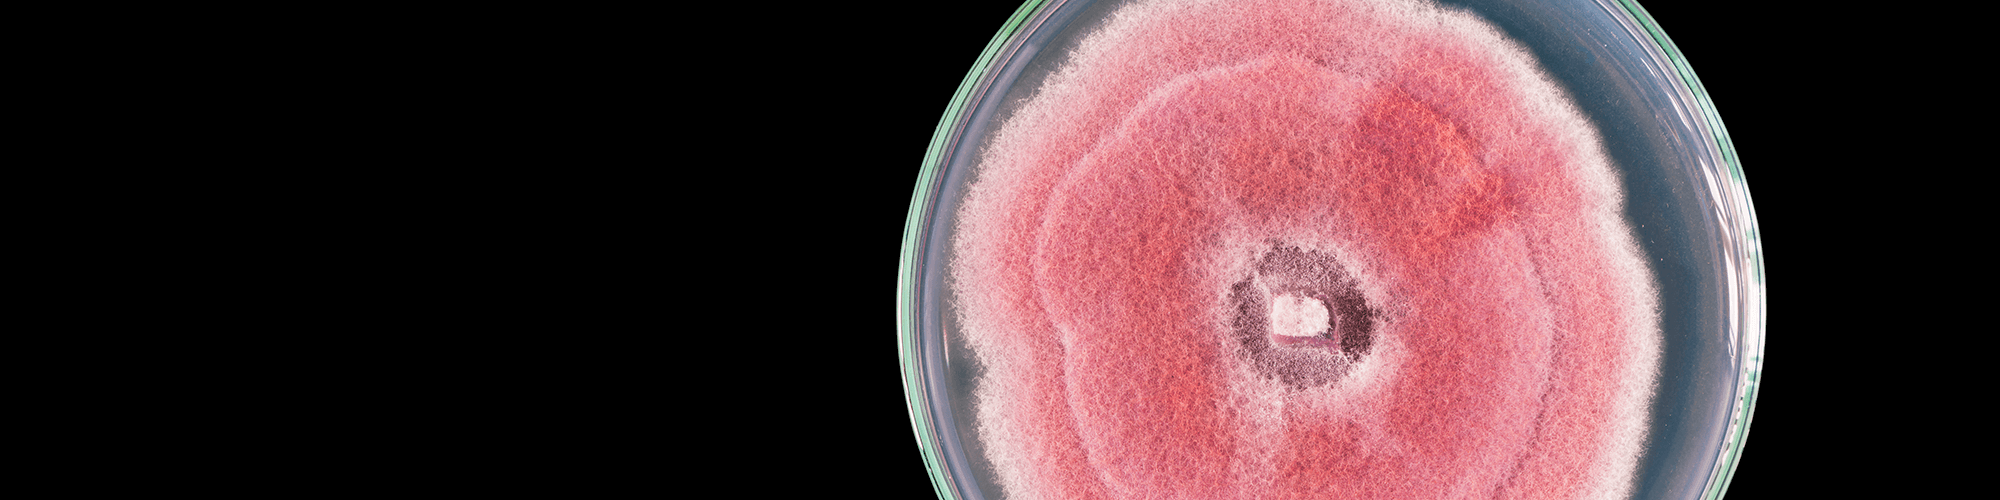
Raw Material

content

Agaricus blazei
Agaricus blazei is a kind of edible fungi plants, taste sweet, almond aroma. Agaricus blazei common in nutrition and health food, and claimed to ...
Antrodia cinnamomea
Antrodia cinnamomea, also known as “ Niu-chang-chih ” or “Chang-chih ” is a medicinal fungus unique to Taiwan. ...

Antrodia cinnamomea
Armillaria mellea belongs to an edible and medicinal mushroom of the Tricholomataceae family that is found worldwide. ...
Cordyceps cicadae mycelium
Cordyceps cicadae, also known as “ Cicada flower ” or “Chanhua ” or “ Sandwhe ”, belongs to the family Clavicipitaceae and the genus Cordyceps. C. ...

Cordyceps militaris
Cordyceps militaris, also known as north Chinese caterpillar fungus, is one of the most valuable substitutes of Cordyceps sinensis. ...
Coriolus versicolor
Coriolus versicolor, an ideal culinary-medicinal mushroom, has a long history of medicinal usage in China. In particular, hot water extracted ...
Ganoderma lucidum
Ganoderma lucidum, also known as “Lingzi” or “Reishi” is a native fungus from China, has been widely used in China and other Asian ...
Coriolus versicolor
Coriolus versicolor, an ideal culinary-medicinal mushroom, has a long history of medicinal usage in China. In particular, hot water extracted ...
Hirsutella sinensis
Hirsutella sinensis is a medicinal fungus used for centuries in Asian countries as a health supplement. Our fermentation ...

Lactobacillus
Grape King Bio is the largest production company for kinds of lactic acid bacteria in Taiwan, with daily production over 20 tons ...
Lignosus rhinocerotis
Lignosus rhinocerotis, also known as the tiger milk mushroom, is regarded as an important local medicinal mushroom in Malaysia where it has long..
Paecilomyces hepiali
Cordyceps sinensis is a famous and expensive traditional Chinese medicine. Paecilomyces hepiali, also known as caterpillar ...
Phellinus linteus
Medicinal mushroom Phellinus linteus is a famous fungus which is widely used in Asian countries to prevent ailments as diverse as ..